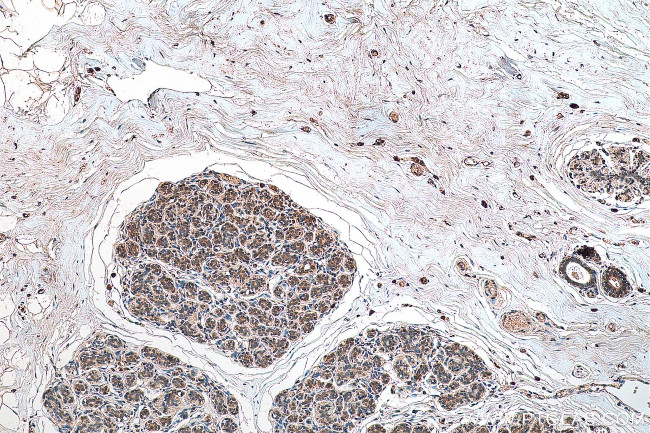
C1orf27 Antibody in Immunohistochemistry (Paraffin) (IHC (P))

Search
Proteintech
C1orf27 Polyclonal Antibody
{{$productOrderCtrl.translations['antibody.pdp.commerceCard.promotion.promotions']}}
{{$productOrderCtrl.translations['antibody.pdp.commerceCard.promotion.viewpromo']}}
{{$productOrderCtrl.translations['antibody.pdp.commerceCard.promotion.promocode']}}: {{promo.promoCode}} {{promo.promoTitle}} {{promo.promoDescription}}. {{$productOrderCtrl.translations['antibody.pdp.commerceCard.promotion.learnmore']}}
产品信息
22844-1-AP
种属反应
宿主/亚型
分类
类型
抗原
偶联物
形式
浓度
纯化类型
保存液
内含物
保存条件
运输条件
产品详细信息
Immunogen sequence: NALRRLMFA VEKSINRKRL WNFTEEEVSE RVTLHICAST KKIFCRTYDI HDPKSSARPA DWKYQSGLSS SWLSLECTVH INIHIPLSAT SVSYTLEKNT KNGLTRWAKE IENGVYLING QVKDEDCDLL EGQ (106-237 aa encoded by BC003397)
靶标信息
May play a role in the trafficking of a subset of G-protein coupled receptors.
仅用于科研。不用于诊断过程。未经明确授权不得转售。
生物信息学
蛋白别名: hODR-4; LAG1-interacting protein; mODR-4; odorant response abnormal 4; olfactory specific odr-4; Protein odr-4 homolog; transactivated by recombinant transforming growth factor beta; Transactivated by transforming growth factor beta protein 1
基因别名: 1810053E15Rik; C1orf27; odr-4; ODR4; TTG1; TTG1A
UniProt ID: (Mouse) Q4PJX1, (Human) Q5SWX8
Entrez Gene ID: (Mouse) 226499, (Human) 54953